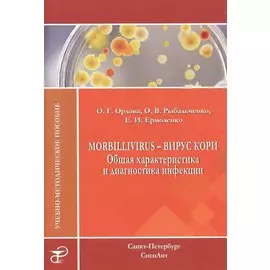
Morbillivirus - вирус кори. Общая характеристика и диагностика инфекции: учебно-методическое пособие

-
 СпецЛит1342 ₽
СпецЛит1342 ₽Анатомия спинномозговых нервов и доступы к ним. Ханна А. | Данная книга является полноценным иллюстрированным пособием, посвященным хирургическим доступам к периферическим нервам. В каждой главе разоб...
-
 СпецЛит437 ₽
СпецЛит437 ₽Английский язык в сфере профессионального общения. Стоматология: Учебное пособие. (на английском языке). Колобаев В.К. | Учебное пособие предназначено для студентов стоматологических факультетов и вуз...
-
 СпецЛит1204 ₽
СпецЛит1204 ₽Биология. Современный курс. 4-е издание, исправлено и дополнено. Под ред. Никитина А.Ф. | Пособие содержит все разделы курса общей биологии в объеме программы средней школы и соответствует требованиям...
-
 СпецЛит365 ₽284 ₽-22%
СпецЛит365 ₽284 ₽-22%Периферическая нервная система. Автономная нервная система. Органы чувств. Рабочая тетрадь | Данное пособие является английской версией учебника профессора И. В. Гайворонского "Нормальная анатомия чел...
-
 СпецЛит471 ₽367 ₽-22%
СпецЛит471 ₽367 ₽-22%Медикаментозное лечение эпилепсии у детей | В учебном пособии рассматривается проблема медикаментозного лечения эпилепсии у детей. Представлена новая классификация эпилепсии, краткая обобщенная информ...
-
 СпецЛит1415 ₽1103 ₽-22%
СпецЛит1415 ₽1103 ₽-22%Анестезия и интенсивная терапия при критических состояниях. Базовые технологии. Учебное пособие | В учебном пособии рассматриваются основные физиологические константы, важные для анестезиолога-реанима...
-
 СпецЛит589 ₽459 ₽-22%
СпецЛит589 ₽459 ₽-22%Топография органов в таблицах и схемах: учебное пособие | Учебне пособие содержит данные о границах, содержимом и сообщениях клетчаточных пространств тела человека, топографии различных областей тела,...
-
 СпецЛит3459 ₽
СпецЛит3459 ₽Дерматовенерология | В учебнике рассмотрены основные нозологические формы дерматозов и инфекций, передаваемых половым путем, отдельный раздел посвящен основам дерматоонкологии, раскрыты современные пр...
-
![Психическое и профессиональное здоровье. Психологическая диагностика и коррекция. Учебное пособие для врачей]() СпецЛит1769 ₽1379 ₽-22%
СпецЛит1769 ₽1379 ₽-22%Психическое и профессиональное здоровье. Психологическая диагностика и коррекция. Учебное пособие для врачей | В пособии изложены актуальные аспекты психического и профессионального здоровья, работосп...
-
![Практическая психогигиена: учебно-методическое пособие]() СпецЛит471 ₽353 ₽-25%
СпецЛит471 ₽353 ₽-25%Практическая психогигиена: учебно-методическое пособие | В пособии изложены актуальные аспекты практической психогигиены. Представлены рекомендации по основным разделам индивидуальной психогигиены: во...
-
![Раневой процесс: нанобиотехнологии оптимизации]() СпецЛит589 ₽459 ₽-22%
СпецЛит589 ₽459 ₽-22%Раневой процесс: нанобиотехнологии оптимизации | На основе данных мировой литературы, результатов собственных клинических и экспериментальных исследований в настоящем издании изложены современные пред...
-
![Герпесвирусная инфекция Особенности проявлений... Уч. пос. (2 изд) (м) Каспина]() СпецЛит365 ₽284 ₽-22%
СпецЛит365 ₽284 ₽-22%Герпесвирусная инфекция Особенности проявлений... Уч. пос. (2 изд) (м) Каспина | В учебном пособии систематизированы сведения о характеристиках разных типов герпесвирусов, с современных позиций изложе...
-
![Диагностика и лечение ранений шеи]() СпецЛит1096 ₽855 ₽-21%
СпецЛит1096 ₽855 ₽-21%Диагностика и лечение ранений шеи | Предлагаемая вашему вниманию монография составлена на основании опыта авторов по лечению пострадавших с различными вариантами повреждений органов шеи в практике бол...
-
![Родовая травма головы (основы персонализированной медицинской помощи) : учебное пособие]() СпецЛит589 ₽459 ₽-22%
СпецЛит589 ₽459 ₽-22%Родовая травма головы (основы персонализированной медицинской помощи) : учебное пособие | В учебном пособии рассматривается проблема персонализации медицинской помощи новорожденным детям с родовой тра...
-
![Angiology. The manual for medical students / Ангиология. Учебное пособие для медицинских вузов (специальность "Лечебное дело")]() СпецЛит619 ₽433 ₽-30%
СпецЛит619 ₽433 ₽-30%Angiology. The manual for medical students / Ангиология. Учебное пособие для медицинских вузов (специальность "Лечебное дело") | Данное пособие является английской версией учебника профессора И. В. Га...
-
![Руководство к практическим занятиям по инфекционным болезням для студентов медицинских вузов]() СпецЛит1769 ₽1379 ₽-22%
СпецЛит1769 ₽1379 ₽-22%Руководство к практическим занятиям по инфекционным болезням для студентов медицинских вузов | Данное руководство является первым издающимся в России учебным пособием к практическим занятиям для студе...
-
![Доврачебная неотложная помощь: учебное пособие]() СпецЛит471 ₽367 ₽-22%
СпецЛит471 ₽367 ₽-22%Доврачебная неотложная помощь: учебное пособие | Данное пособие составлено с учетом содержания программы подготовки студентов факультетов: лечебного, педиатрического, спортивной медицины, высшего сест...
-
![Поражения внутренних органов вирусной и хламидийной инфекцией в практике терапевта: руководство для врачей]() СпецЛит1415 ₽1103 ₽-22%
СпецЛит1415 ₽1103 ₽-22%Поражения внутренних органов вирусной и хламидийной инфекцией в практике терапевта: руководство для врачей | Эта книга о том, как уберечь сердце от заболеваний, как его восстановить в том случае, если...
-
![Инструментальная диагностика в неврологии. Руководство для врачей]() СпецЛит3421 ₽2667 ₽-22%
СпецЛит3421 ₽2667 ₽-22%Инструментальная диагностика в неврологии. Руководство для врачей | В руководстве обобщены основные современные представления об инструментальной диагностике поражений центральной и периферической нер...
-
![Анатомия здорового и нездорового образа жизни]() СпецЛит1651 ₽1287 ₽-22%
СпецЛит1651 ₽1287 ₽-22%Анатомия здорового и нездорового образа жизни | В книге в доступной форме представлены сведения о строении и функциях человеческого организма в норме, а также об изменениях при наиболее распространенн...
-
![Бактериальные вагинозы]() СпецЛит2241 ₽1747 ₽-22%
СпецЛит2241 ₽1747 ₽-22%Бактериальные вагинозы | Бактериальный вагиноз представляет собой дисбиоз нижнего отдела женского репродуктивного тракта, однако он может являться причиной ряда патологий, к которым относятся преждевр...
-
![Анализ электрокардиограммы у детей раннего возраста с врожденными пороками сердца: учебное пособие]() СпецЛит471 ₽353 ₽-25%
СпецЛит471 ₽353 ₽-25%В учебном пособии рассматривается анализ электрокардиограммы у детей раннего возраста с врожденными пороками сердца. В современной медицине многие операции по поводу таких пороков проводятся в младенч...
-
![Психология развития человека: рождение и жизнь]() СпецЛит2005 ₽1563 ₽-22%
СпецЛит2005 ₽1563 ₽-22%Психология развития человека: рождение и жизнь | В первой части книги представлены теоретико-методологические основы психологии развития и возрастной психологии, используемые в них методы исследования...
-
![Неизвестная анатомия: учебное пособие]() СпецЛит287 ₽239 ₽-16%
СпецЛит287 ₽239 ₽-16%Неизвестная анатомия: учебное пособие | Учебное пособие свещает несколько основных разделов анатомии человека, раскрывающих возрастные особенности, закономерности роста и развития организма, особеннос...
-
![Нейротравматология (с позиции трехуровневой системы оказания помощи) : руководство для врачей]() СпецЛит1415 ₽1103 ₽-22%
СпецЛит1415 ₽1103 ₽-22%Нейротравматология (с позиции трехуровневой системы оказания помощи) : руководство для врачей | Руководство посвящено актуальным вопросам лечения пациентов с черепно-мозговой, позвоночно-спинномозгово...
-
![Травматические повреждения мягких тканей челюстно-лицевой области. Клиника, диагностика и лечение : учебное пособие]() СпецЛит376 ₽282 ₽-25%
СпецЛит376 ₽282 ₽-25%Травматические повреждения мягких тканей челюстно-лицевой области. Клиника, диагностика и лечение : учебное пособие | Пособие посвящено актуальной проблеме травматических повреждений мягких тканей чел...
-
![Лечение волос в косметологии]() СпецЛит1415 ₽1103 ₽-22%
СпецЛит1415 ₽1103 ₽-22%Лечение волос в косметологии | Представляемое учебное пособие написано на основе анализа обширной литературы и собственного опыта автора. На сегодняшний день оно является наиболее полным в отечественн...
-
![Болезни сердечно-сосудистой системы. Клиника, диагностика и лечение. Гериатрические аспекты в кардиологии. Учебное пособие]() СпецЛит1592 ₽1241 ₽-22%
СпецЛит1592 ₽1241 ₽-22%В учебном пособии рассматриваются особенности заболеваний сердечно-сосудистой системы у пожилых людей и методы их лечения, с использованием современных данных.
-
![Оплата труда медицинских работников.Учебное пособие.]() СпецЛит565 ₽441 ₽-21%
СпецЛит565 ₽441 ₽-21%Оплата труда медицинских работников.Учебное пособие. | Разработка положения об оплате труда персонала в настоящее время является одной из актуальных проблем для каждой медицинской .организации, в связ...
-
![Внутрипросветная хирургия грудной и брюшной полостей]() СпецЛит825 ₽643 ₽-22%
СпецЛит825 ₽643 ₽-22%Внутрипросветная хирургия грудной и брюшной полостей | В издании на основе эндоскопической картины описана внутрипросветная анатомия органов груди и живота, а также внутрипросветные операции при ряде ...
-
![Функциональная и ультразвуковая диагностика в неврологии и нейрохирургии]() СпецЛит6371 ₽4967 ₽-22%
СпецЛит6371 ₽4967 ₽-22%Функциональная и ультразвуковая диагностика в неврологии и нейрохирургии | В условиях современной медицины все большую роль играет инструментальная диагностика. Ранее основную нагрузку в клинической н...
-
![Эволюция стрептококковой инфекции: руководство для врачей]() СпецЛит919 ₽717 ₽-21%
СпецЛит919 ₽717 ₽-21%Эволюция стрептококковой инфекции: руководство для врачей | В руководстве представлены современные данные по этиологии, эпидемиологии и патогенезу стрептококковой инфекции. Изложены клиническая картин...
-
![Основы стоматологии]() СпецЛит919 ₽717 ₽-21%
СпецЛит919 ₽717 ₽-21%Основы стоматологии | Пособие написано на основе многолетнего опыта преподавания курса стоматологии в Ленинградском санитарно-гигиеническом медицинском институте (ныне Северо-Западный государственный ...
-
![Нейромультидисциплинарные болезни. Научно-практическое руководство]() СпецЛит825 ₽643 ₽-22%
СпецЛит825 ₽643 ₽-22%Нейромультидисциплинарные болезни. Научно-практическое руководство | Книга посвящена описанию новых возможностей медицины в ведении неврологических больных. Определены новые методы и основные черты по...
-
![Детские болезни. Том 1]() СпецЛит5781 ₽4507 ₽-22%
СпецЛит5781 ₽4507 ₽-22%Детские болезни. Том 1 | Совершенствование оказания медицинской помощи детям имеет непреходящее значение и высокую актуальность. В книге освещены ключевые аспекты программирования здоровья и лечения б...
-
![Внелегочный туберкулез: руководство для врачей]() СпецЛит1155 ₽901 ₽-21%
СпецЛит1155 ₽901 ₽-21%Внелегочный туберкулез: руководство для врачей | В руководстве для врачей изложены вопросы клиники, диагностики, дифференциальной диагностики, терапевтического и хирургического лечения туберкулеза вне...
-
![Поведение:эволюционный подход]() СпецЛит287 ₽239 ₽-16%
СпецЛит287 ₽239 ₽-16%Поведение:эволюционный подход | В книге с эволюционных позиций освещаются все разделы, связанные с поведением: этиология, нейрофизиология, теория научения и мотивации. Показана методологическая роль г...
-
![Заболевания печени и желчевыводящих путей : руководство для врачей]() СпецЛит707 ₽551 ₽-22%
СпецЛит707 ₽551 ₽-22%Заболевания печени и желчевыводящих путей : руководство для врачей | В руководстве с современных позиций освещены основные разделы гепатологии, заболеваний билиарной системы: анатомо-функциональные ос...
-
![Эндодонтическое лечение зубов: методология и технология. Учебное пособие]() СпецЛит1037 ₽778 ₽-24%
СпецЛит1037 ₽778 ₽-24%Эндодонтическое лечение зубов: методология и технология. Учебное пособие | В пособии изложены современные представления об эндодонтии в прикладном значении для клинической практики. В доступной для вр...
-
![Хрестоматия по философии]() СпецЛит1356 ₽1057 ₽-22%
СпецЛит1356 ₽1057 ₽-22%Хрестоматия по философии | Данная хрестоматия представляет собой антологию тематически сгруппированных философских текстов - извлечений из трудов мыслителей разных эпох. Создана на основе программы по...
-
![Клиника, диагностика и лечение основных ревматических болезней. Учебное пособие]() СпецЛит1592 ₽1241 ₽-22%
СпецЛит1592 ₽1241 ₽-22%Клиника, диагностика и лечение основных ревматических болезней. Учебное пособие | В учебном пособии приведены сведения по эпидемиологии, клинической картине заболеваний, критериям их диагностики, дифф...
-
![Наиболее употребительные словообразовательные элементы названий лекарственных средств. Тематические карточки]() СпецЛит1155 ₽901 ₽-21%
СпецЛит1155 ₽901 ₽-21%Наиболее употребительные словообразовательные элементы названий лекарственных средств. Тематические карточки | Активно усвоить грамматику, вопросы терминообразования и лексику — это значит овладеть ум...
-
![Аутоагрессия и самойубийство при алкогольной зависимости:клиника и психотерапия]() СпецЛит825 ₽643 ₽-22%
СпецЛит825 ₽643 ₽-22%Аутоагрессия и самойубийство при алкогольной зависимости:клиника и психотерапия | В монографии с позиций доказательной медицины получает дальнейшее развитие концепция алкогольной зависимости как аутоа...
-
![Особенности педиатрической фармации: Фармацевтическая технология и фармакологические аспекты : учебное пособие]() СпецЛит825 ₽643 ₽-22%
СпецЛит825 ₽643 ₽-22%Особенности педиатрической фармации: Фармацевтическая технология и фармакологические аспекты : учебное пособие | В пособии рассмотрены вопросы, объясняющие необходимость наличия специальных детских ле...
-
![Болезни кишечника. Клиника, диагностика и лечение. Учебное пособие]() СпецЛит1356 ₽1057 ₽-22%
СпецЛит1356 ₽1057 ₽-22%Болезни кишечника. Клиника, диагностика и лечение. Учебное пособие | В учебном пособии отражены современные взгляды на этиологию, патогенез, классификации основных заболеваний кишечника. Приведены све...
-
![Практикум по неотложной хирургии органов брюшной полости. Учебное пособие]() СпецЛит1356 ₽1057 ₽-22%
СпецЛит1356 ₽1057 ₽-22%Практикум по неотложной хирургии органов брюшной полости. Учебное пособие | Неотложная хирургия органов брюшной полости - важная и сложная проблема абдоминальной хирургии. Больные с "острым животом" п...
-
![Эндокринология : руководство для врачей. Том 1 Заболевания гипофиза, щитовидной железы и надпочечников.]() СпецЛит919 ₽689 ₽-25%
СпецЛит919 ₽689 ₽-25%В руководстве для врачей представлены сведения об анатомии и физиологии эндокринной системы, а также основы гормональной регуляции. Рассмотрены заболевания гипофиза, щитовидной железы и надпочечников.
-
![Пациентоведение]() СпецЛит365 ₽274 ₽-24%
СпецЛит365 ₽274 ₽-24%Пациентоведение | Истории о морально-этической стороне взаимоотношений между врачом и пациентом, написанные практикующим мануальным терапевтом, основаны на реальных событиях. Автор уверен, что, несмот...
-
![Методология исследования в клинической психологии: учебное пособие]() СпецЛит1356 ₽1057 ₽-22%
СпецЛит1356 ₽1057 ₽-22%Методология исследования в клинической психологии: учебное пособие | Пособие посвящено методологии исследования в клинической психологии. Рассматривается подготовительный этап исследования, особое вни...
-
![Хирургия молочной железы: руководство для врачей]() СпецЛит1238 ₽965 ₽-22%
СпецЛит1238 ₽965 ₽-22%Хирургия молочной железы: руководство для врачей | В руководстве содержатся основные сведения об этиологии, патогенезе, клинике и современной диагностике наиболее часто встречающихся в лечебной практи...
-
![Справочник по неврологии]() СпецЛит1592 ₽1241 ₽-22%
СпецЛит1592 ₽1241 ₽-22%Справочник по неврологии | В справочнике приведены современные сведения по основным вопросам клинической неврологии. Рассмотрены этиология, патогенез, клинические проявления с учётом возрастных аспект...
-
![Экстрапирамидные расстройства-вчера,сегодня,завтра]() СпецЛит1651 ₽1287 ₽-22%
СпецЛит1651 ₽1287 ₽-22%Экстрапирамидные расстройства-вчера,сегодня,завтра | «Данное издание представляет собой сборник публикаций сотрудников Центра экстрапирамидных заболеваний при кафедре неврологии РМАПО, которые показал...
-
![Гигиена Издание 2]() СпецЛит2595 ₽2023 ₽-22%
СпецЛит2595 ₽2023 ₽-22%Гигиена Издание 2 | В учебнике систематизированы современные теоретические и практические данные по гигиене. Представлены исторические и методологические основы гигиены, дана гигиеническая характерист...
-
![Инсульт.Срочная реабилитация]() СпецЛит589 ₽459 ₽-22%
СпецЛит589 ₽459 ₽-22%Инсульт.Срочная реабилитация | Клиника, критерии диагностики и экспертизы. Тактика ведения и реабилитация. Данное издание является научным практическим руководством по тактике ведения и реабилитации б...
-
![Morbillivirus - вирус кори. Общая характеристика и диагностика инфекции: учебно-методическое пособие]() СпецЛит287 ₽239 ₽-16%
СпецЛит287 ₽239 ₽-16%Morbillivirus - вирус кори. Общая характеристика и диагностика инфекции: учебно-методическое пособие | В учебном пособии изложены сведения о систематике и строении Morbillivirus, особенностях репродук...
-
![Гастродуоденальные язвы и хронический гастрит (гастродуоденит)]() СпецЛит1037 ₽809 ₽-21%
СпецЛит1037 ₽809 ₽-21%Гастродуоденальные язвы и хронический гастрит (гастродуоденит) | В настоящей монографии авторами предпринята попытка на основании анализа собственных и литературных данных критически оценить существую...
-
![Лечение травматических вывихов бедра и их последствий : учебно-методическое пособие]() СпецЛит287 ₽215 ₽-25%
СпецЛит287 ₽215 ₽-25%Лечение травматических вывихов бедра и их последствий : учебно-методическое пособие | Данное пособие предназначено, в первую очередь, для врачей трав-матологов-ортопедов и хирургов центральных районны...
-
![Нормальная анатомия человека. Учебник для медицинских вузов в 2-х томах. Том 1]() СпецЛит3775 ₽2943 ₽-22%
СпецЛит3775 ₽2943 ₽-22%Нормальная анатомия человека. Учебник для медицинских вузов в 2-х томах. Том 1 | Все разделы учебника «Нормальная анатомия человека» написаны с позиций функциональной морфологии. Материал изложен крат...
-
![Диагностика пародонтита: учебное пособие]() СпецЛит1037 ₽809 ₽-21%
СпецЛит1037 ₽809 ₽-21%Диагностика пародонтита: учебное пособие | Авторами освещены вопросы одного из направлений терапевтической стоматологии — пародонтологии. Подробно изложены вопросы анатомии пародонта и методы диагност...
-
![Альгология в стоматологии]() СпецЛит424 ₽330 ₽-22%
СпецЛит424 ₽330 ₽-22%Альгология в стоматологии | В монографии обобщены данные литературы, а также многолетний опыт авторов, касающиеся изучения различных заболеваний полости рта, при которых главным симптомом является бол...
-
![Избранные лекции по клинической психиатрии. Учебное пособие]() СпецЛит1887 ₽1471 ₽-22%
СпецЛит1887 ₽1471 ₽-22%Избранные лекции по клинической психиатрии. Учебное пособие | В учебное пособие, подготовленное коллективом кафедры психиатрии Военно-медицинской академии им. С. М. Кирова, включены лекции, освещающие...
-
![Психология влюбленных]() СпецЛит424 ₽330 ₽-22%
СпецЛит424 ₽330 ₽-22%Психология влюбленных | Эта книга — манифест влюбленных. Она призывает не считать влюбленность психическим расстройством, а принимать ее как общечеловеческое достояние, имеющее первостепенную ценность...
-
![Хирургические инфекции груди и живота]() СпецЛит2005 ₽1563 ₽-22%
СпецЛит2005 ₽1563 ₽-22%Хирургические инфекции груди и живота | Руководство является фундаментальным трудом, обобщающим современные достижения в диагностике и лечении хирургических инфекций груди и живота. В работе изложены ...
-
![Неотложные ситуации в кардиохирургии. Методическое пособие для ординаторов]() СпецЛит589 ₽459 ₽-22%
СпецЛит589 ₽459 ₽-22%Неотложные ситуации в кардиохирургии. Методическое пособие для ординаторов | В кардиохирургии неотложные ситуации встречаются нередко. Операции, выполненные по неотложным показаниям, сопровождаются бо...
Каталог бренда Спецлит
Категории Спецлит
Вы находитесь на странице бренда Спецлит. Ниже представлен каталог оригинальных продуктов, который включает в себя товары в количестве 1140 шт., из различных интернет-магазинов, осуществляющих доставку в пределах России. Ассортимент может включать как доступные по цене товары, так и продукцию люксового сегмента.
Для бренда "Спецлит" найдено товаров: 1140
Цена:
Люди часто ищут
Физиология
Кардиология
Неврология
Фармакология
Право
Психиатрия
Хирургия
Справочники
Анатомия
Педиатрия
Биология
Технология
Стоматология
Английские
Психотерапия
Психология
Акушерство
Литература
Терапия
Английский язык
Категории Спецлит